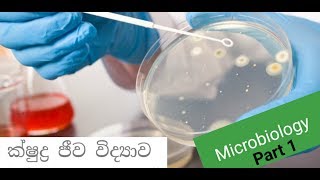

Undergraduate Biology
In this channel, you guys can learn about biology lessons
Shared 7 months ago
7 views
Shared 1 year ago
117 views
Shared 2 years ago
135 views
Shared 4 years ago
11 views
Shared 6 years ago
1.6K views
Shared 6 years ago
80 views
Shared 6 years ago
359 views
Shared 6 years ago
88 views
Shared 6 years ago
283 views
Shared 6 years ago
379 views